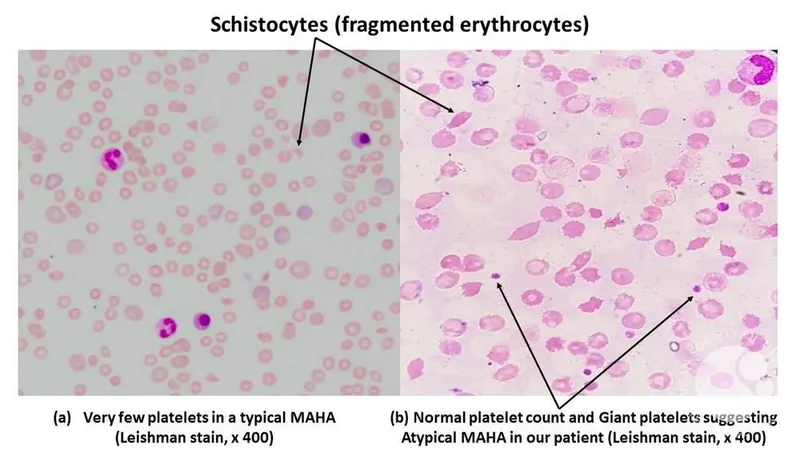
Schistocytes in MAHA peripheral blood smear

Hemolytic Uremic Syndrome: Overview - Tiny Clots, Big Trouble
-
Definition: A critical illness defined by the triad of microangiopathic hemolytic anemia (MAHA), thrombocytopenia (platelet count < 150,000/μL), and acute kidney injury (AKI).
-
📌 Classic Triad: HUS = RAT (Renal failure, Anemia, Thrombocytopenia).
-
Key Types & Etiology:
Feature Typical (D+) HUS Atypical (aHUS / D-) HUS Prevalence ~90% of cases; common in children < 5 years. ~10% of cases; can occur at any age. Main Cause Shiga toxin-producing E. coli (STEC), esp. O157:H7; Shigella dysenteriae. Primarily genetic mutations leading to chronic, uncontrolled complement activation. Other triggers: infections (non-enteric), drugs. Prodrome Usually follows acute gastroenteritis with bloody diarrhea (D+). Often no preceding diarrhea (D-); may have insidious onset or be triggered by infections.
⭐ HUS is the most common cause of acute kidney injury (AKI) in young children.
Hemolytic Uremic Syndrome: Pathophysiology - Endothelial Attack Mode
HUS pathogenesis is driven by Shiga toxin (Stx) from bacteria like EHEC. Stx targets vascular endothelial cells, primarily in renal glomeruli and the brain, initiating a damaging cascade.

- Toxin Action: Stx absorption from the gut allows it to bind endothelial Gb3 receptors.
- Cellular Impact: This triggers endothelial damage, apoptosis, and inflammation.
- Vascular Occlusion: Leads to microthrombi in small vessels (glomeruli).
- Systemic Effects: Results in consumption of platelets (thrombocytopenia), mechanical RBC damage (schistocytes), and ultimately renal ischemia and AKI.
⭐ Shiga toxin (Stx) binds with high affinity to the glycosphingolipid globotriaosylceramide (Gb3) receptor, predominantly expressed on renal glomerular endothelial cells.
Hemolytic Uremic Syndrome: Clinical & Lab Dx - Spotting the Syndrome
Clinical Presentation:
- Prodrome:
- D+ HUS (Typical): Diarrhea (often bloody) post-gastroenteritis (E. coli O157:H7).
- D- HUS (Atypical/Pneumococcal): Recent URI (S. pneumoniae).
- Key Symptoms: Pallor, weakness, oliguria/anuria, edema, hypertension.
- Severe Signs: Petechiae/purpura, irritability, seizures (CNS involvement).
Key Laboratory Findings:
| Test Category | Finding | Significance |
|---|---|---|
| CBC | Anemia (Hb <8-10 g/dL), Thrombocytopenia (<150,000/μL) | MAHA, Platelet consumption |
| Peripheral Smear | Schistocytes, helmet cells | RBC fragmentation (hallmark of MAHA) |
| Hemolysis | ↑LDH, ↓Haptoglobin, ↑Indirect Bilirubin | Intravascular hemolysis |
| Renal Function | ↑BUN, ↑Creatinine; Hematuria, Proteinuria | Acute Kidney Injury (AKI) |
| Specific Tests | Stool (Shiga toxin), ADAMTS13, Complement | Identify cause (D+ HUS, TTP diff., aHUS) |
Hemolytic Uremic Syndrome: Management & Complications - Damage Control & Outlook
⭐ Antibiotic treatment of EHEC infections is generally avoided as it may increase Shiga toxin release and worsen HUS risk; supportive care is the cornerstone for typical (D+) HUS.
Management: Mainstay is supportive care for D+ HUS.
- Fluid/electrolyte balance (⚠️ caution fluid overload).
- RBC transfusion if Hb <6-7 g/dL.
- Platelet transfusion: ONLY for active, severe bleeding (NOT prophylactic).
- Nutritional support.
- Hypertension control.
- Dialysis for severe AKI.
- aHUS: Eculizumab.
- AVOID: Antibiotics/antimotility agents in D+ HUS.
Complications:
- CNS: Seizures, stroke.
- GI: Colitis, perforation.
- Pancreatitis.
- Renal: CKD, hypertension, proteinuria.
Prognosis: Better in D+ HUS with prompt management.

High-Yield Points - ⚡ Biggest Takeaways
- HUS Triad: Microangiopathic hemolytic anemia (MAHA), thrombocytopenia, and acute kidney injury (AKI).
- Typical HUS (D+ HUS): Caused by Shiga toxin-producing E. coli (STEC), often O157:H7, after bloody diarrhea.
- Pathophysiology: Toxin-mediated endothelial damage causes microthrombi in renal microvasculature.
- Key lab finding: Schistocytes on peripheral smear, indicating MAHA.
- Management: Primarily supportive. Avoid antibiotics and antimotility agents in D+ HUS.
- Atypical HUS (aHUS): Due to complement dysregulation; may need eculizumab.
Unlock the full lesson and continue reading
Signup to continue reading this lesson and unlimited access questions, flashcards, AI notes, and more